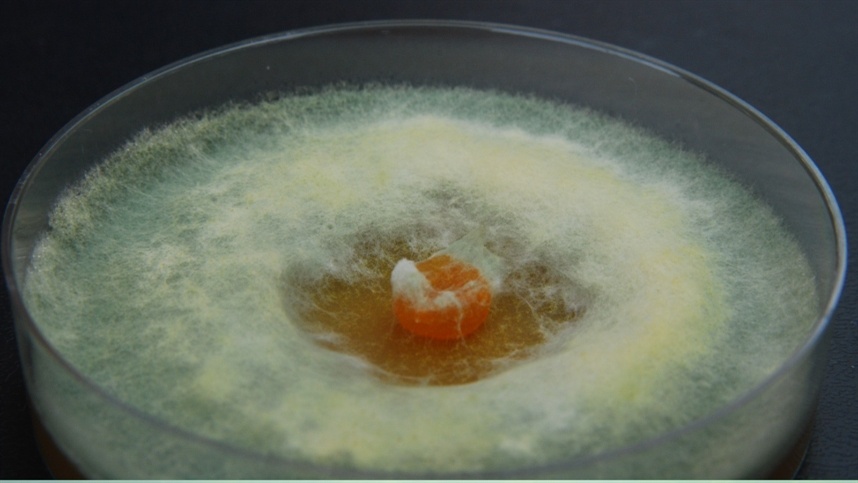

Empresa obtém R$ 38,7 milhões para pesquisas em biotecnologia, sustentabilidade e inovação agropecuária
A Embrapa teve três projetos aprovados na chamada de Institutos Nacionais de Ciência e Tecnologia (INCT) 2024, conforme resultado final divulgado pelo CNPq. A chamada, com investimento total de R$ 1,63 bilhão, foi a maior da história do programa, com a ampliação em 20%, com suplementação do Fundo Nacional de Desenvolvimento Científico e Tecnológico (FNDCT) e de Fundações de Amparo à Pesquisa (FAPs). Os projetos da Empresa conquistaram um aporte conjunto de R$ 38,7 milhões.
O maior valor aprovado, de R$ 14,3 milhões, será destinado ao “INCT MicroAgro: Inovações biotecnológicas com microrganismos para uma agricultura produtiva e sustentável”, coordenado pela pesquisadora Mariangela Hungria, da Embrapa Soja. O projeto foca em inovações científicas e desenvolvimento biotecnológico relacionadas ao uso de microrganismos multifuncionais para promover uma agricultura mais produtiva e sustentável, contribuindo para a redução do uso de insumos químicos e o aumento da eficiência dos sistemas agrícolas.
Segundo Mariângela Hungria, o projeto tem por objetivo principal promover inovação científica e desenvolvimento biotecnológico, realizar ações de comunicação e formar recursos humanos em linhas de pesquisa relacionadas a microrganismos multifuncionais. A iniciativa conta com uma equipe de mais de 180 membros de 21 grupos em nove Unidades Descentralizadas da Embrapa, além de 12 instituições de Pesquisa, Ensino e Universidades Públicas, em todas as regiões.
“Foram delineados 16 objetivos específicos com 44 metas e previsão de 48 tipos de entregas, desde a bioprospecção, manutenção, com acreditação, estudos “ômicos” com microrganismos e lançamento de bioinsumos, passando pelo melhoramento clássico e assistido de plantas hospedeiras, até uma forte ação em comunicação”, explica Mariangela Hungria. A pesquisadora destaca ainda a realização de parcerias público-privadas para ações de comunicação e codesenvolvimento tecnológico com 22 empresas, associações, cooperativas e com 27 instituições nos cinco continentes para o avanço no conhecimento.
A pesquisadora ressalta que o projeto pretende atender o crescimento das demandas do setor intensificadas após o lançamento do Programa Nacional de Bioinsumos, em 2020. “O INCT MicroAgro contribuirá para colocar o Brasil não só na liderança de uso, mas também em inovação em bioinsumos.”
Outro destaque é o INCT-EngBio – Instituto Nacional de Ciência e Tecnologia em Engenharia de Sistemas Biológicos, liderado por Elíbio Rech, pesquisador da Embrapa Recursos Genéticos e Biotecnologia, que conquistou a nota máxima (10) e receberá R$ 12,5 milhões.
Segundo Elíbio Rech, o INCT-EngBio representa uma tendência científica global em biotecnologia, melhorando o papel do Brasil nesse campo emergente. Ele explica que o projeto foi construído sobre as bases estabelecidas do INCT-BioSyn desde 2014. “O INCT-EngBio integra biotecnologia, biodiversidade, inteligência artificial, aprendizado de máquina e computação quântica para enfrentar desafios ambientais e mudanças climáticas”, destaca.
O projeto envolve 11 pesquisadores de dez instituições em todo o Brasil e pretende promover uma abordagem sistêmica que combina pesquisa de ponta, formação de recursos humanos e inovação tecnológica. “O objetivo geral do INCT-EngBio é aplicar princípios de engenharia a sistemas biológicos, utilizando tanto o desenho in silico clássico quanto quântico para enfrentar desafios contemporâneos em um contexto de Big Data. O instituto visa melhorar a qualidade da soja por meio de engenharia metabólica, produzindo óleo com maior teor de ácido oleico e menor teor de ácido palmítico, o que beneficia tanto a produção de biodiesel quanto a saúde humana. Além disso, ele aproveitará a inteligência artificial e algoritmos para acelerar a aquisição de dados metagenômicos e facilitar a produção de proteínas sintéticas em sistemas livres de células”, explica.
De acordo com Elíbio Rech, o INCT-EngBio também está comprometido em formar recursos humanos em vários níveis educacionais e promover a disseminação do conhecimento por meio de atividades educacionais para estudantes e o público em geral. “O instituto incentivará colaborações científicas e tecnológicas, incluindo consórcios internacionais e parcerias com sociedades científicas, ao mesmo tempo em que se concentrará na proteção da propriedade intelectual gerada durante suas atividades de pesquisa.”
O terceiro projeto da Embrapa aprovado pela chamada do CNPq, o Instituto Nacional de Ciência e Tecnologia (INCT – Gado de Corte), é coordenado por Rodrigo da Costa Gomes, da Embrapa Gado de Corte e pelo professor Dalton Henrique Pereira, da Universidade Federal de Mato Grosso (UFMT). Com recursos aprovados de R$ 11,8 milhões, a iniciativa busca promover o avanço no conhecimento e desenvolver soluções tecnológicas como respostas aos principais desafios para a produção de carne bovina no Brasil.
“Espera-se ainda evoluir o processo de melhoramento genético animal e também as práticas de reprodução para promover a eficiência e resiliência dos rebanhos bovinos brasileiros frente aos desafios climáticos e ambientais impostos e, também, a estruturação de uma plataforma de inteligência baseada em ciência de dados e inteligência artificial, para suporte aos diferentes atores da cadeia da carne bovina”, afirma Rodrigo Gomes.
Para isso, a equipe estabeleceu 40 metas, com entregas que envolvem cultivares forrageiras, bioinsumos e sistemas de produção para intensificação sustentável e descarbonização, além de softwares, soluções para inspeção sanitária e tecnologias para a vigilância de doenças, visando à promoção da segurança sanitária da carne brasileira em padrões internacionais.
Gomes explica que o INCT será estruturado a partir de seis redes de PD&I que centrarão esforços nas frentes de pastagens, inteligência estratégica, saúde animal, melhoramento genético animal, reprodução animal e descarbonização. “Três dessas redes são lideradas pela Embrapa Gado de Corte e outras três pelas Universidades Federais de Mato Grosso do Sul, Minas Gerais e Rio Grande do Sul, com representantes de 16 universidades, dois institutos de pesquisa e envolvimento de 131 profissionais, incluindo pesquisadores do país e do exterior.
No total, foram submetidas 651 propostas, sendo 143 aprovadas. A contratação dos projetos deve ocorrer em agosto, quando os trabalhos terão início com vigência de cinco anos.
Os três projetos aprovados obtiveram notas variando de 9,55 a 10,0. Outros sete projetos apresentados por Unidades Descentralizadas da Embrapa também tiveram sua qualidade destacada no edital final da chamada, mas não obtiveram recursos de financiamento.
Fonte: AGROLINK